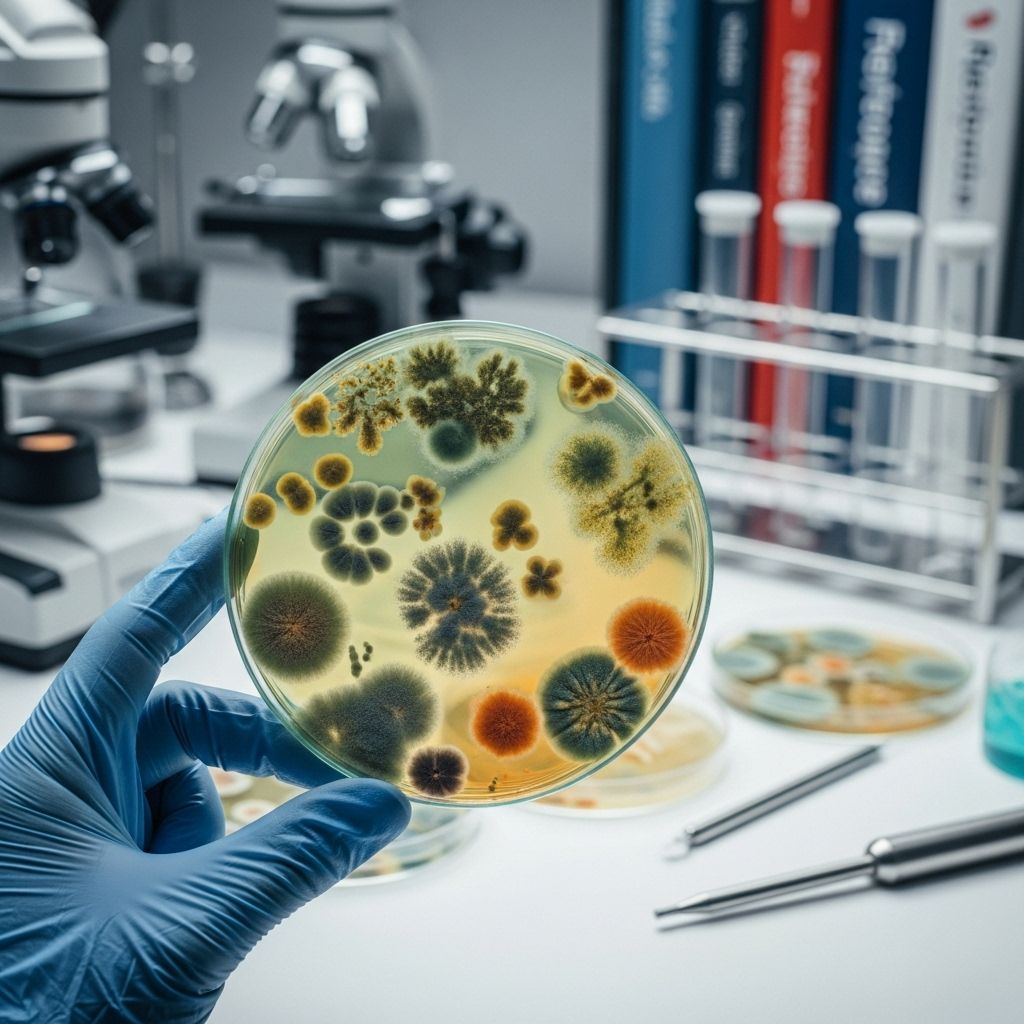
Fungal Infections: Types, Symptoms, Diagnosis, and Prevention Learn about fungal infections, their symptoms, treatment options, and practical ways to prevent them affecting your health.

Fungal Infections: Types, Symptoms, Diagnosis, and Prevention
Learn about fungal infections, their symptoms, treatment options, and practical ways to prevent them affecting your health.
Fungal infections are a broad category of illnesses caused by different types of fungi. These microscopic organisms exist everywhere in the environment and on the human body. While most fungi are harmless, some can trigger mild skin conditions or severe, even life-threatening internal diseases, particularly in those with weakened immune systems. Understanding the types, symptoms, diagnostic methods, and prevention strategies for fungal infections can help you protect your health and seek effective treatment when needed.
What Are Fungal Infections?
Fungal infections occur when harmful fungi invade and multiply in the body. Fungi are plant-like organisms found in air, water, soil, and on living surfaces. There are numerous species of fungi, but only a fraction cause illness in humans. Some fungi naturally reside in our bodies and may cause infection if their growth becomes uncontrolled. Infections range from superficial, affecting the skin, nails, or mucous membranes, to systemic, involving internal organs and requiring prompt medical attention.
Where Do Fungi Live?
- On the skin, nails, and hair
- Inside the body, such as in the mouth or intestines
- Outdoors in soil, plants, and dust
- Indoors on surfaces, in the air, and damp environments
Although most people are regularly exposed to fungal spores, only some develop infections—often those with specific risk factors such as a compromised immune system, diabetes, or prolonged antibiotic use.
Types of Fungal Infections
Fungal infections are typically categorized based on the body part or system they affect. They can be grouped broadly into superficial (surface-level) and systemic (deep or organ-based) infections. The most common types include:
Superficial Fungal Infections
- Tinea (Dermatophytosis): A group of infections affecting the skin, hair, or nails. Examples include:
- Ringworm (Tinea corporis): Circular, itchy red rashes on the body.
- Athlete’s foot (Tinea pedis): Itching, burning, and cracked skin between toes.
- Jock itch (Tinea cruris): Rash in groin and inner thighs, often in athletes.
- Scalp ringworm (Tinea capitis): Scaly patches on the scalp, leading to hair loss.
- Yeast Infections (Candidiasis): Caused mostly by Candida species.
- Oral thrush: White patches inside the mouth.
- Vaginal yeast infections: Itching, soreness, and discharge in the vaginal area.
- Candidiasis of the skin: Red, itchy patches often in moist areas like armpits or under breasts.
- Fungal Nail Infections (Onychomycosis): Yellow, thick, brittle, or deformed nails, more common in toenails than fingernails.
Systemic Fungal Infections
- Aspergillosis: Caused by Aspergillus species, affects lungs and can spread to other organs—more common in immunocompromised individuals.
- Cryptococcosis: Often seen in people with weak immune systems, such as HIV/AIDS patients.
- Coccidioidomycosis (Valley fever): Contracted by inhaling spores from Coccidioides fungus in the soil.
- Histoplasmosis: Acquired by inhaling spores from bird or bat droppings in certain areas.
Symptoms of Fungal Infections
Symptoms depend on the type of fungus and location of infection. While some infections are mild and limited to the skin, others can be serious and affect internal organs.
| Infection Type | Common Symptoms |
|---|---|
| Skin and Nail Infections |
|
| Oral or Vaginal Yeast Infections |
|
| Systemic Infections |
|
Some fungal infections cause symptoms that mimic bacterial or viral illnesses, making laboratory testing crucial for accurate diagnosis.
Diagnosis of Fungal Infections
Diagnosis typically involves a combination of clinical examination and laboratory tests. Different tests are used based on the suspected type and location of the infection.
- Physical Exam: Visual inspection of nails, skin, mouth, or genitals for classic fungal signs.
- Microscopy: Scrapings from skin, nails, or mucous membranes viewed under a microscope to detect fungal cells.
- Culture Tests: Samples (skin, nail, blood, sputum, urine, other body fluids) are incubated to promote fungal growth, helping identify the exact fungus and guide treatment. Results may take several days to weeks.
- Other Laboratory Tests: Additional tests (e.g., susceptibility testing, imaging studies) may be necessary for systemic or resistant infections.
Your medical provider may order a fungal culture when symptoms are not improving, infection is deep or severe, or to rule out similar conditions. Rapid testing methods may be applied for urgent cases.
Treatment of Fungal Infections
Treatment depends on the type, severity, and location of the fungal infection. The main therapeutic approaches include:
- Topical Antifungal Medications: Creams, ointments, lotions, or powders applied directly to the affected skin or nails. These are typically used for mild or superficial infections, such as athlete’s foot, jock itch, ringworm, or some nail infections.
- Oral Antifungal Drugs: Pills or capsules are prescribed for more severe or widespread infections, or when topical therapies are ineffective. Examples include terbinafine, itraconazole, and fluconazole. Oral antifungals are commonly used for fungal nail infections or systemic disease.
- Intravenous (IV) Antifungals: Reserved for life-threatening or deep-seated infections, especially in hospitalized or immunocompromised patients.
- Susceptibility Testing: When the infection is stubborn or does not respond to standard drugs, lab testing helps determine which antifungal works best for the specific organism.
- Removal Procedures: In rare, difficult cases, removal of part or all of a nail, or surgical cleaning of infected tissues, may be necessary.
Note: Over-the-counter remedies can help for minor skin infections but are often ineffective against more severe fungal diseases. Always consult a healthcare professional if symptoms persist, recur, or worsen.
Risk Factors for Fungal Infections
Anyone can develop a fungal infection, but certain factors increase risk, including:
- Weakened immune system (due to illness, medications, or HIV/AIDS)
- Diabetes
- Poor personal hygiene
- Prolonged use of antibiotics or corticosteroids
- Wearing tight or non-breathable footwear
- Warm, humid environments
- Direct or indirect contact with infected individuals, surfaces, or animals
Can Fungal Infections Be Prevented?
You can reduce your risk of developing or spreading fungal infections by taking these practical steps:
- Keep skin clean and dry, especially in skin folds and between toes
- Change socks and underwear daily
- Wear shoes that allow your feet to “breathe” and avoid prolonged dampness
- Trim nails short and keep them clean
- Avoid walking barefoot in public showers, locker rooms, and pool areas
- Do not share towels, shoes, or personal items
- Practice good oral hygiene to prevent oral thrush
- Wash your hands after touching animals or soil
- If you notice a rash or nail change in a pet, seek veterinary advice as animals can transmit fungal infections like ringworm
When to See a Healthcare Provider
Consult your doctor or healthcare provider if you have:
- Persistent rash, scaling, or discoloration unresponsive to over-the-counter antifungals
- Severe discomfort, pain, or signs of spreading infection
- Fever, shortness of breath, or serious systemic symptoms
- Compromised immunity or chronic conditions like diabetes
A timely diagnosis can help prevent complications, alleviate discomfort, and speed recovery.
Frequently Asked Questions (FAQs) About Fungal Infections
What causes fungal infections?
Fungal infections are caused by different types of fungi, including molds, yeasts, and dermatophytes. They thrive in warm, moist environments or when the body’s natural protective mechanisms are impaired.
How are fungal infections diagnosed?
Diagnosis usually involves a physical examination, viewing microscope samples, and laboratory culture tests from the affected area. In addition, susceptibility testing and blood cultures are used for deeper or persistent infections.
Are fungal infections contagious?
Some types, such as ringworm or nail fungus, can spread from person to person, through contaminated surfaces, or via animals. Good hygiene and not sharing personal items help reduce risk.
Can you treat fungal infections at home?
Mild skin infections sometimes respond to over-the-counter antifungal creams or sprays. If the infection persists, worsens, or spreads, medical evaluation and prescription medicines may be needed.
Why do fungal nail infections take so long to clear?
Nail infections are challenging to treat because antifungal agents penetrate the nail slowly. Even after treatment, it may take up to a year for healthy nails to replace infected ones. Recurrence is common, so preventive care is important.
Are fungal infections dangerous?
Most superficial fungal infections are mild and treatable, but serious or systemic infections can be life-threatening, especially in people with weakened immune systems. Prompt medical attention is critical in severe cases.
Quick Facts About Fungal Infections
- Fungi may live harmlessly on the skin but can cause infection if allowed to multiply unchecked.
- Not all rashes or skin changes are caused by fungi; other infections can mimic them.
- Effective treatment depends on accurate diagnosis and sometimes laboratory identification of the fungus.
- Prevention relies on good personal hygiene, early treatment, and minimizing risk factors.
References and Further Reading
- Centers for Disease Control and Prevention (CDC) – Fungal Diseases
- MedlinePlus – Fungal Infections
- American Academy of Dermatology – Fungal Skin Infections
Read full bio of medha deb












